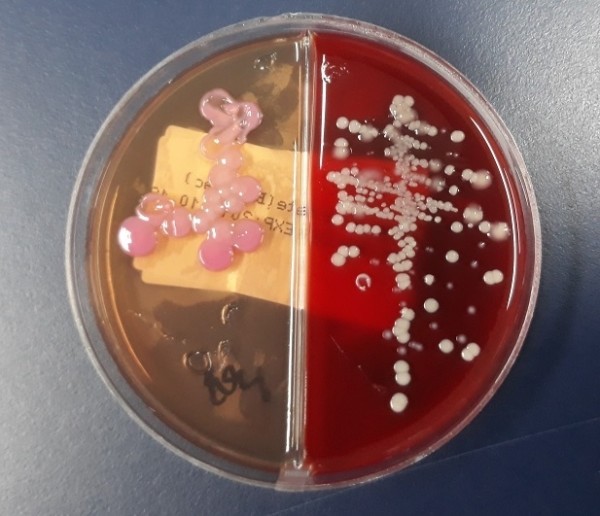

질병관리청 통계에 따르면, 항생제내성 감염병인 CRE 감염증 관련 전국 신고 건수는 2018년 1만1953건, 2019년 1만5369건으로 매년 증가하고 있으며, 올해도 11월까지 1만5088건으로 지난해 동기 대비 986건 많았다.
특히 CRE 감염증 중 고령 인구가 차지하는 비율은 지속적으로 증가해 2020년 6월 기준 70세 이상이 전체의 62%에 달했으며, 요양병원 신고 비율도 2018년 4%에서 2020년 10%로 증가했다.
이러한 사실은 의료기관의 감염관리가 잘 이뤄지지 않을 경우, 코로나19 확산세가 이어지는 지금 시기에 감염취약계층의 코로나19의 집단감염과 세균 동시감염 및 2차 감염에 대한 우려를 더욱 높이고 있다.
대전시의 경우, 올해 11월 말 현재 CRE 감염증 신고에 따른 연구원 확인검사 현황은 208건(양성 188건), 2019년 169건(양성 154건), 2018년 103건(양성 90건)으로 매년 증가되고 있다.
이는 지난해 동기 대비 검사의뢰 건수는 33.3%, 이 중 양성으로 확인된 경우는 30.6%의 증가를 보이고 있어서 감염 예방관리에 더욱 주의가 요구된다.
대전시 전재현 보건환경연구원장은 “CRE 감염증은 사용가능한 항생제를 제한해 고령 환자의 경우 사망률에도 영향을 끼치므로 감염관리 원칙을 준수하는 것이 중요하다”며 “대전시 보건환경연구원은 2년 연속 항생제내성 감염병에 대한 외부평가에서 ‘우수’를 획득한바, 앞으로도 검사의 신뢰성 제고와 의료기관 내 집단발생 내성균의 유전형을 분석해 역학적 연관성 규명 등 방역조치에 필요한 데이터 제공에 힘쓰겠다”고 밝혔다.
한편, 카바페넴 내성 장내세균속균종은 카바페넴계 항생제에 내성을 나타내는 장내세균속균종, 카바페넴계 항생제에 대한 내성은 주로 카바페넴분해효소생성, 항생제의 유출 및 세포막의 투과성 감소 등에 의해 나타난다.